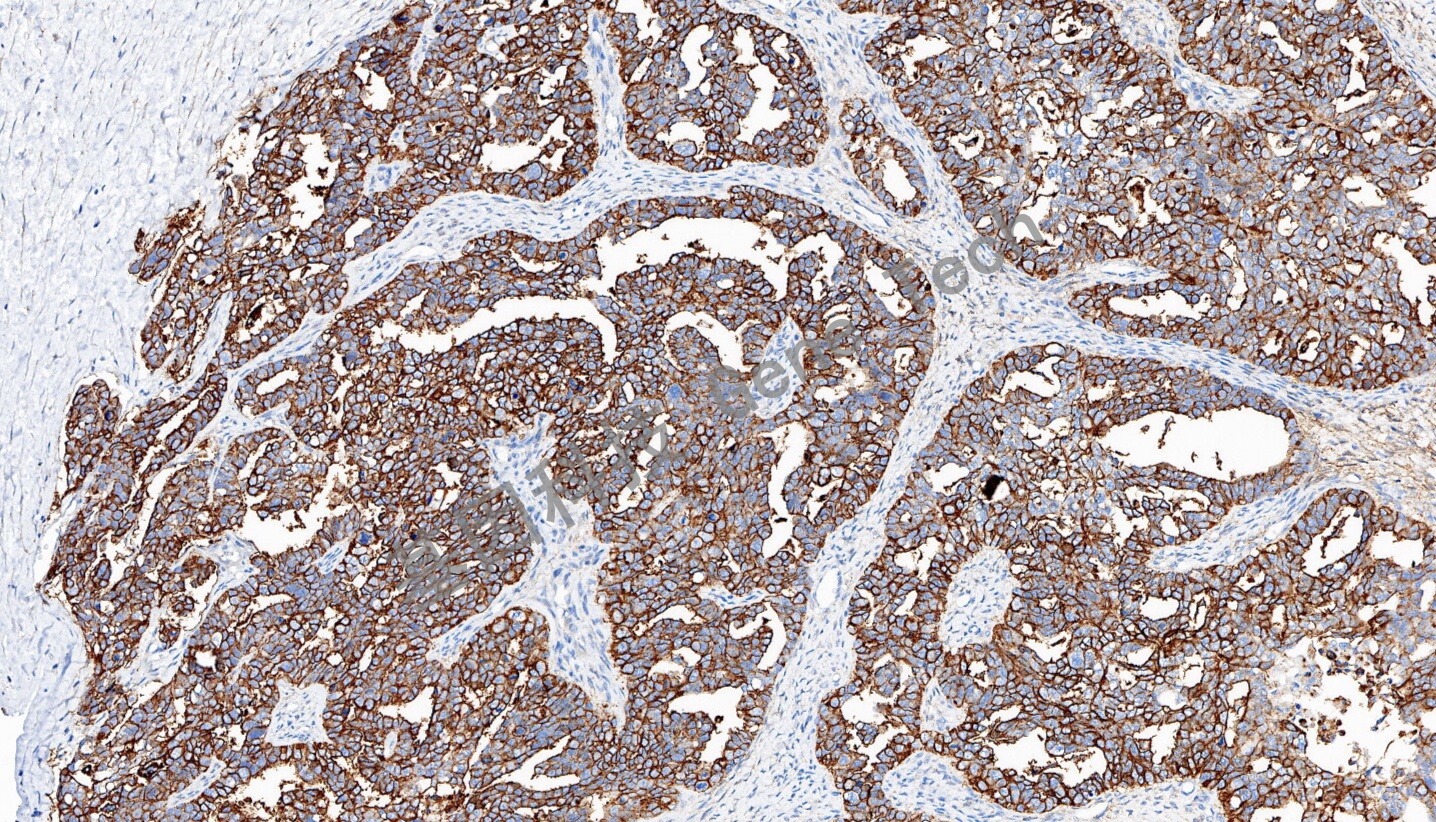
1701069842114957.jpg

产品中心
Products
产品中心
Products
CD47 兔抗人 CD47 抗体试剂(免疫组织化学法)
浏览次数:208 发布时间:2023-11-27
| 沪闵械备20220116号 | ||
| 克隆号:GR112 | 种属:兔 | 适用染色系统:GTvisionTM |
| 预处理:高pH热修复 | 阳性部位:细胞膜 | 阳性对照:卵巢癌 |
| 简介:CD47又称整合素相关蛋白(Integrin-associated protein, IAP),是一种跨膜蛋白,在正常组织和多种肿瘤组织中广泛表达。 CD47具自我识别、调控免疫反应、血细胞识别和肿瘤逃避免疫等生物学功能。 CD47表达升高与卵巢癌、乳腺癌、结肠癌、膀胱癌、肝癌、肺癌等癌症生存期降低相关,可作为预后标志物,也是潜在的免疫治疗靶点。 | ||
| ||
| 卵巢癌石蜡切片,用 CD47(GT2501)染色,细胞膜阳性,DAB 显色。 | ||
| 货号 | GT250102 | GT250107 |
| 规格 | 2.0ml | 7.0ml |



